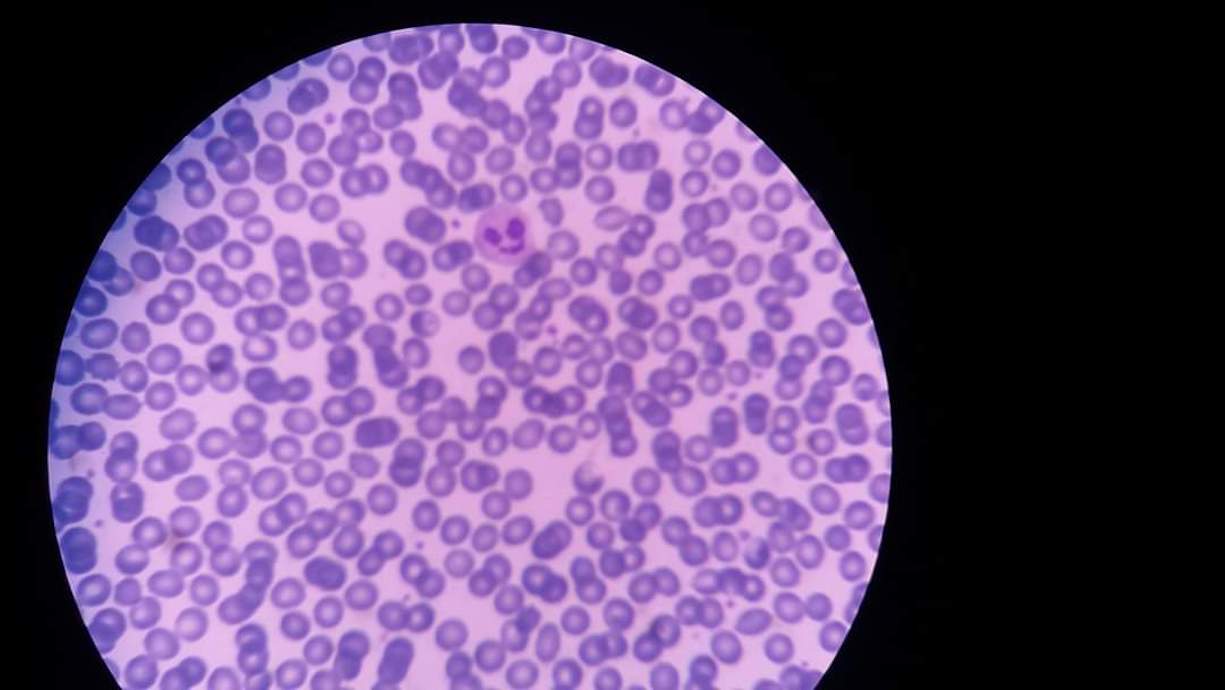

Ο χώρος του Medicus Lab είναι σχεδιασμένος με προσοχή ώστε να προσφέρει άνεση και ασφάλεια.
Με άρτια εξοπλισμένο εργαστήριο και υποδομή φιλική προς τον ασθενή, εξασφαλίζουμε την καλύτερη δυνατή εμπειρία.
Το Medicus Lab συστεγάζεται στο ισόγειο της οδού Αγίου Χριστοφόρου 5, στο Αγρίνιο, μαζί με:
το Καρδιολογικό Ιατρείο του Καρδιολόγου Δημητρίου Κώτσα,
και το Ιατρείο Υπερήχων της Ακτινολόγου Χριστίνας Παρμάκη.
Ο χώρος είναι λειτουργικός, φιλόξενος και εύκολα προσβάσιμος, με ενιαίο και προσεγμένο χώρο υποδοχής και αναμονής, προσφέροντας άμεση, συντονισμένη και ολοκληρωμένη εξυπηρέτηση των εξεταζομένων.
Το ιατρείο έχει ποιοτικό έλεγχο σε συνεργασία με τον Μedisyn και εγγυάται την αξιοπιστία των αποτελεσμάτων.